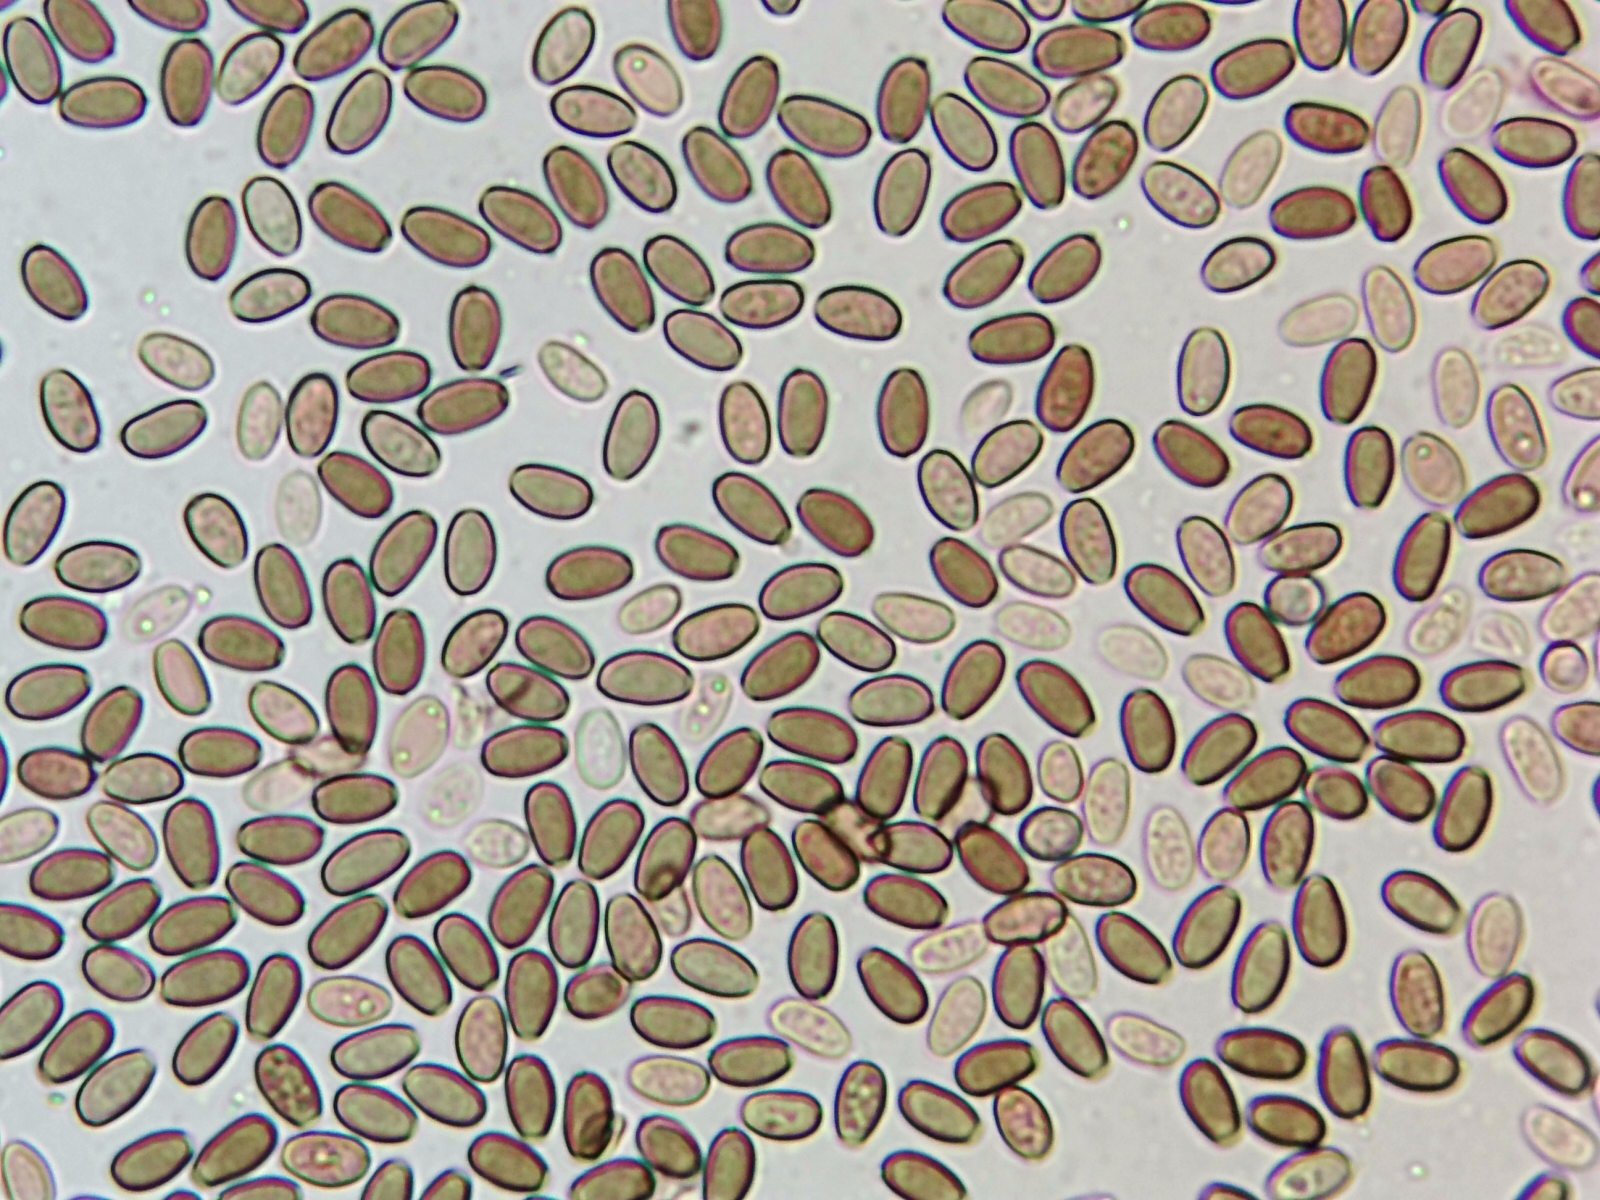

Psathyrella candolleana
Psathyrella candolleana
- javier
-
 Autor del tema
Autor del tema
- Fuera de línea
- Moderador
-

Menos
Más
- Mensajes: 5617
- Gracias recibidas: 4356
3 años 11 meses antes - 3 años 11 meses antes #107295
por javier
Psathyrella candolleana Publicado por javier
Adjuntos:
Última Edición: 3 años 11 meses antes por javier.
El siguiente usuario dijo gracias: Miguel Ángel, Josep Torres
Por favor, Identificarse para unirse a la conversación.
- Miguel Ángel
-

- Fuera de línea
- Moderador
-

Menos
Más
- Mensajes: 1849
- Gracias recibidas: 519
3 años 11 meses antes #107299
por Miguel Ángel
Respuesta de Miguel Ángel sobre el tema Pashirella candolleana
Buen aporte ,Estas siempre las suelo ver en zonas húmedas conviviendo con algunas otras del mismo genero ,un cordial saludo.
El siguiente usuario dijo gracias: javier
Por favor, Identificarse para unirse a la conversación.
- Josep Torres
-

- Fuera de línea
- Moderador
-

Menos
Más
- Mensajes: 8746
- Gracias recibidas: 8379
3 años 11 meses antes #107307
por Josep Torres
Respuesta de Josep Torres sobre el tema Pashirella candolleana
Gracias Javier, bonito aporte, esta es a mi modo de entender la más común de todas, de cada 10 Psathyrellas con sombrero de color crema que recojo muestra en nueve ocasiones me sale la dichosa candolleana, a destacar como característica la ausencia de pleurocistidios, en estos momentos dispongo de 11 microscopías de la misma.
Por cierto echa un vistazo al título del tema ya que hay un evidente "baile de letras" es Psathyrella no "Pashirella"
Un abrazo
Por cierto echa un vistazo al título del tema ya que hay un evidente "baile de letras" es Psathyrella no "Pashirella"
Un abrazo
El siguiente usuario dijo gracias: javier
Por favor, Identificarse para unirse a la conversación.
- javier
-
 Autor del tema
Autor del tema
- Fuera de línea
- Moderador
-

Menos
Más
- Mensajes: 5617
- Gracias recibidas: 4356
3 años 11 meses antes #107311
por javier
Respuesta de javier sobre el tema Psathyrella candolleana
El siguiente usuario dijo gracias: Josep Torres
Por favor, Identificarse para unirse a la conversación.
Tiempo de carga de la página: 0.097 segundos

Foro de micología